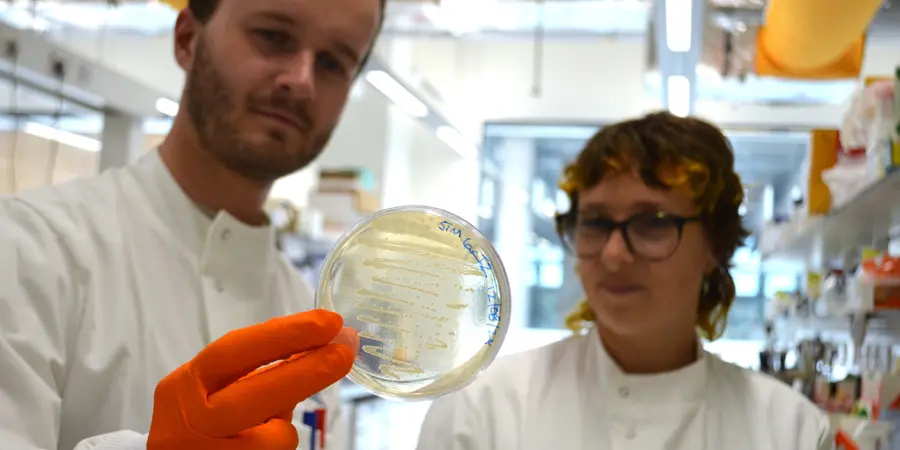

With humans being sent to space for over 60 years, there has been lots of research into how the human body responds to extended space travel. But more recently, scientists have started to wonder how other lifeforms respond to microgravity, even extending to the organisms that we cannot see with the naked eye.
The conditions on the International Space Station (ISS) are unlike anything you could find on Earth: increased radiation and vibrations, not to mention the lack of gravity. This is why scientists are testing how microscopic life, that has adapted to conditions on the Earth over billions of years, copes with the ISS: an environment that is totally alien to its entire evolutionary history.
Introducing: Bacteria!
Microscopic single-celled organisms called bacteria are found almost everywhere: on your skin, on surfaces, in water, and even on the ISS! Not all bacteria are harmful; in fact, most are either neutral or beneficial to humans and the environment. However, with the fact that we know little about the bacteria present on the ISS, and how disease-causing bacteria (pathogens) may respond to its environment, there has been a push for extensive research into this area so that we can learn from the research for future space travel.

What’s already there?
One of the biggest questions is: what microorganisms can we actually find on board? Where did they come from?
To answer these questions, astronauts on the ISS swabbed numerous different surfaces on the station. When the swabs came back to Earth, the bacteria on the swabs were allowed to grow and the scientists characterised the species present.
The vast majority of the bacteria that they found were species that are often found on/in humans – part of what is called “the human microbiome”. Such species that they found include Staphylococci, often found on the skin, and Micrococcus which are the bacteria that causes the odour from sweat.

However, interestingly, they also discovered bacteria that are not associated with the human microbiome but are often found in soil samples. Researchers concluded that they were most likely to have come from one of the numerous plants that are brought to the ISS for experiments.
However, unless the astronauts have a very weakened immune system, or if the bacteria gets into somewhere it shouldn’t be (e.g. a cut), then none of the species of bacteria that they found were anything to be concerned about.
What about disease-causing bacteria?
Scientists have therefore researched into how bacteria that do cause disease, called pathogenic bacteria, respond to the ISS environment.
Containing the pathogenic bacteria within a sealed vessel, so that they don’t accidentally contaminate the ISS, researchers investigated how Salmonella, a type of bacteria that typically causes food poisoning, behaves on board.
By comparing the behaviour of identical strains of Salmonella grown in space compared to those grown on Earth, scientists observed that, unsurprisingly, the bacteria had triggered what’s called a stress response. This is when the bacteria detect a stressful condition and turn on many pathways (like switching on a circuit) in order to protect themselves and survive.
However, in turning on this stress response, the Salmonella were deemed to be more virulent – they could more readily cause disease. This response to space was found to be similar in many other species, but not all.
For example, Staphylococcus aureus, a pathogen that can cause skin infections (and is increasingly becoming resistant to antibiotic treatment), was shown to be less virulent when grown in microgravity compared to normal Earth conditions.
Therefore, it appears that a more individual response would be required for different pathogenic bacteria if they were found on board a shuttle used for space missions in the future.
Sticking together: Bacteria are more likely to form a ‘biofilm’ in space
Researchers have also found that many species of bacteria, such as those that can cause food poisoning, E. coli and Salmonella, are more likely to form a biofilm or form a bigger biofilm than on Earth.
A biofilm is when bacteria stick together, and often also stick to a surface, and encase themselves in a ‘shield’ of various components such as sugars and proteins. The production of this structure protects the bacteria from the external environment. As a biofilm can often be quite difficult to penetrate with antibiotics and sanitisers, it means that they are harder to treat compared to bacteria not in a biofilm.
On the Mir orbital station, a Soviet space station that was in orbit from 1986 – 2001, it was reported to have struggled with biofilm growth throughout – on the water recycling systems, rubber hatch locks, and the shower system, to name but a few. It was even found that a biofilm was responsible for the progressive destruction of a window on the Mir’s descent module.
Significant changes have been introduced since the Mir station and the development of the ISS, meaning that many of these issues have been prevented. But the Water Recovery System, used to recycle water from the humidity in the air and even astronauts’ urine, has shown to be an ideal environment for biofilm growth due to the moisture in the system. Overgrowth of bacteria on such systems is clearly an issue and can actually cause blockages and system failures – therefore significant research is ongoing into different materials and surfaces that could prevent biofilm formation, or chemicals that can be added to the system that would not affect the usability of the recycled drinking water – currently iodine is added to keep the biofilm formation at bay.
Looking to the future…
It’s clear that bacteria have a significant, though often unseen, impact on life in space, yet much remains to be understood. If we are to successfully make the leap to long-distance space travel, such as the nine-month voyage to Mars, the research that scientists do now is vital for safeguarding astronaut health and wellbeing. Such research would help us manage a potential threat from pathogenic bacteria, even when we’re millions of miles from Earth.
The CHRISTMAS LECTURES are headed to space!
This year, for the massive 200th anniversary of the CHRISTMAS LECTURES, supported by CGI, we're taking things to a stellar level. Join space scientist Maggie Aderin-Pocock to explore the extraordinary breakthroughs that have revolutionised our understanding of the Universe.
About the author
Joshua Horton is a PhD research student at the Quadram Institute in Norwich.
His research project investigates the regulation of biofilm formation in common foodborne pathogens such as Salmonella. As part of his PhD programme, the NRPDTP supported by the BBSRC, he recently completed a 3-month internship at the Ri with the digital team.
He can be found on Bluesky at @jcihorton.bsky.social
